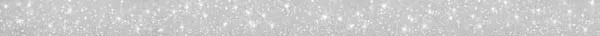

Стекло+камень/керамика из коллекции БОРДЮР УНИВЕРСАЛЬНЫЙ - идеальное решение для оформления интерьера в любом пространстве. Ее можно использовать на улице и для отделки фасадов. Ключевые характеристики: Бренд: Alma Ceramica; страна производства: Россия; форма плитки: прямоугольник, размеры: 3x50x7.5, цвет: серебряный, рисунок: моноколор, применение: для ванной.
Вы сможете реализовать любые идеи в современном стиле, сохранив лаконичность и оригинальность.
* Узнать, есть ли необходимый товар на складе, можно при помощи формы обратной связи или по телефону указному на сайте.
* В реальности товар может выглядеть не так, как на представленном изображении.